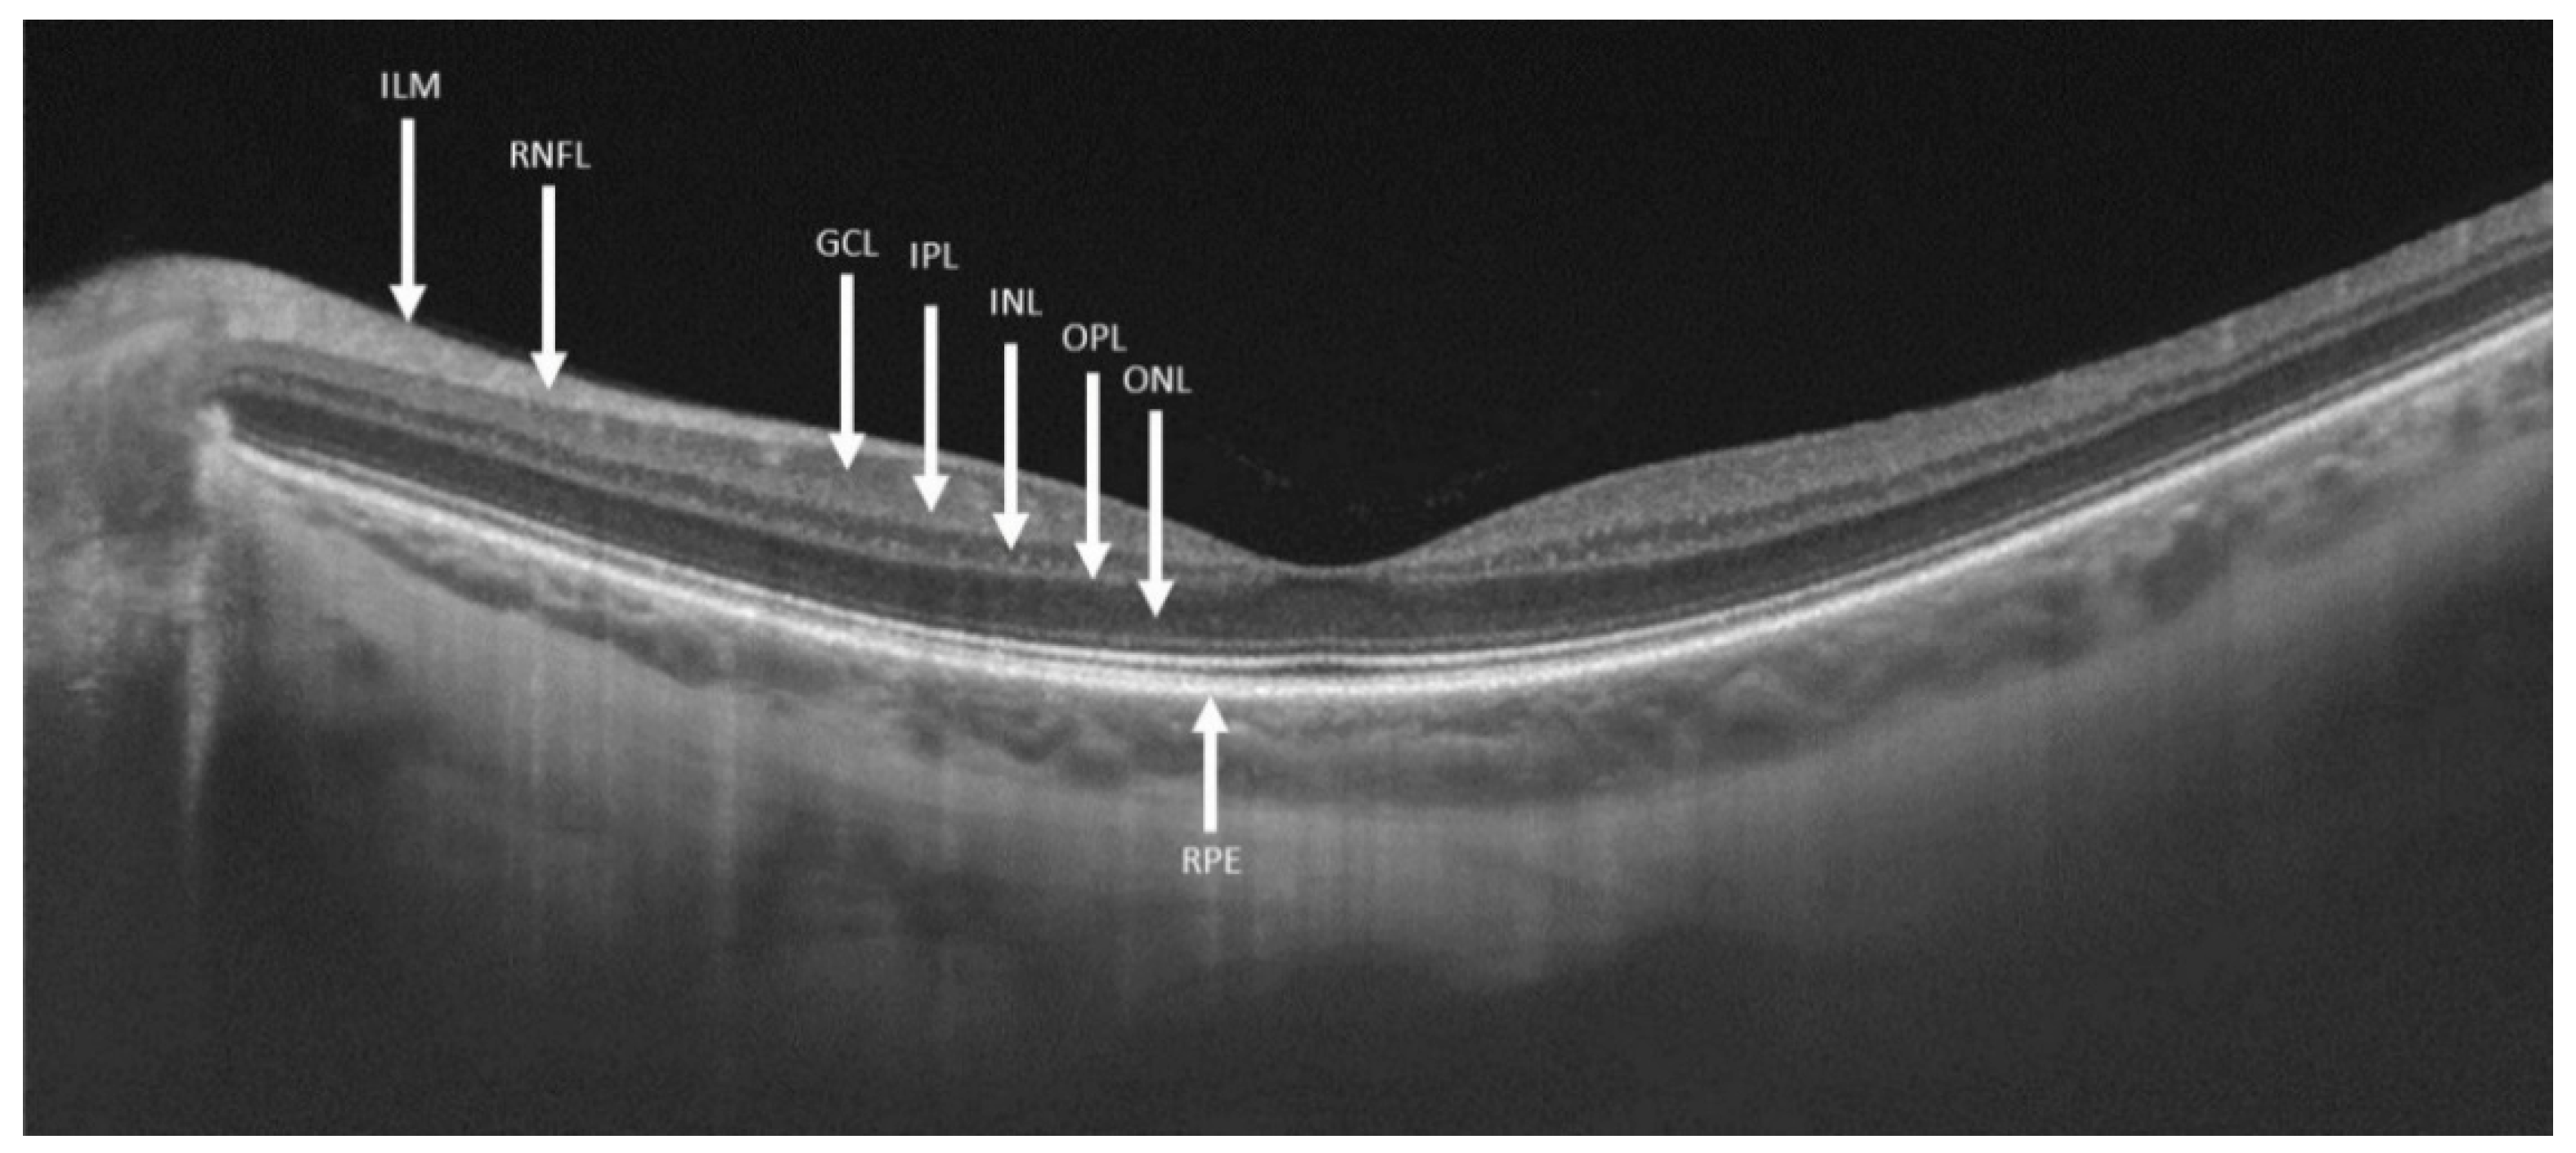
Ijms 21 07027 g001 Ijms 21 07027 g001

Macular Ganglion Cell Complex and Peripapillary Retinal Nerve Fiber Layer Thinning in Patients with Type-1 Gaucher Disease
Abstract
1. Introduction
2. Results
Main Results
3. Discussion
4. Materials and Methods
4.1. Eligibility Criteria
4.2. Study Design
4.3. Statistical Analysis
Supplementary Materials
Author Contributions
Funding
Acknowledgments
Conflicts of Interest
Abbreviations
| GD1 | Type-1 Gaucher disease |
| pRNFL | Peripapillary retinal nerve fiber layer |
| OCT | Optical coherence tomography |
| GCC | Ganglion cell complex |
| ETDRS | Early treatment diabetic retinopathy study |
| GD | Gaucher disease |
| PD | Parkinson disease |
| RGC | Retinal ganglion cells |
| GCL | Ganglion cell layer |
| RNFL | Retinal nerve fiber layer |
| ON | Optic nerve |
| GD3 | Type-3 Gaucher disease |
| ERG | Electroretinogram |
| VEP | Visual evoked potential |
| SZMC | Shaare Zedek Medical Center |
| DBS | Dried blood spot |
| IPL | Inner plexiform layer |
| INL | Inner nuclear layer |
| ILM | Inner limiting membrane |
| RPE | Retinal pigment epithelium |
References
- Abu-Asab, M.S.; Yeung, I.Y.L.; Ardeljan, C.; Gonzalez, A.N.; Sidransky, E.; Chan, C.-C. Ocular Implications of Gaucher Disease. In Advances in Vision Research, Volume I (Essentials in Ophthalmology); Prakash, G., Iwata, T., Eds.; Springer: Tokyo, Japan, 2017; pp. 413–423. [Google Scholar]
- Nalysnyk, L.; Rotella, P.; Simeone, J.C.; Hamed, A.; Weinreb, N. Gaucher disease epidemiology and natural history: A comprehensive review of the literature. Hematology 2017, 22, 65–73. [Google Scholar] [CrossRef] [PubMed]
- Zimran, A.; Elstein, D. Gaucher Disease and Related Lysosomal Storage Diseases. In Williams Hematology; Kaushansky, K., Lichtman, M.A., Prchal, J.T., Levi, M.M., Press, O.W., Burns, L.J., Caligiuri, M., Eds.; McGrawHilll: New York, NY, USA, 2015; pp. 1121–1131. ISBN 9780071833004. [Google Scholar]
- Chérin, P.; Rose, C.; De Roux-Serratrice, C.; Tardy, D.; Dobbelaere, D.; Grosbois, B.; Hachulla, E.; Jaussaud, R.; Javier, R.M.; Noël, E.; et al. The neurological manifestations of Gaucher disease type 1: The French Observatoire on Gaucher disease (FROG). J. Inherit. Metab. Dis. 2010, 33, 331–338. [Google Scholar] [CrossRef]
- Biegstraaten, M.; Wesnes, K.A.; Luzy, C.; Petakov, M.; Mrsic, M.; Niederau, C.; Giraldo, P.; Hughes, D.; Mehta, A.; Mengel, K.E.; et al. The cognitive profile of type 1 Gaucher disease patients. J. Inherit. Metab. Dis. 2012, 35, 1093–1099. [Google Scholar] [CrossRef]
- Capablo, J.L.; Saenz De Cabezón, A.; Fraile, J.; Alfonso, P.; Pocovi, M.; Giraldo, P. Neurological evaluation of patients with Gaucher disease diagnosed as type 1. J. Neurol. Neurosurg. Psychiatry 2008, 79, 219–222. [Google Scholar] [CrossRef]
- Riboldi, G.M.; Di Fonzo, A.B. GBA, Gaucher Disease, and Parkinson’s Disease: From Genetic to Clinic to New Therapeutic Approaches. Cells 2019, 8, 364. [Google Scholar] [CrossRef] [PubMed]
- Neudorfer, O.; Giladi, N.; Elstein, D.; Abrahamov, A.; Turezkite, T.; Achai, E.; Reches, A.; Bembi, B.; Zimran, A. Occurrence of Parkinson’s syndrome in type I Gaucher disease. QJM Int. J. Med. 1996, 89, 691–694. [Google Scholar] [CrossRef]
- Wong, K.; Sidransky, E.; Verma, A.; Mixon, T.; Sandberg, G.D.; Wakefield, L.K.; Morrison, A.; Lwin, A.; Colegial, C.; Allman, J.M.; et al. Neuropathology provides clues to the pathophysiology of Gaucher disease. Mol. Genet. Metab. 2004, 82, 192–207. [Google Scholar] [CrossRef]
- Sidransky, E. Gaucher disease: Complexity in a “simple” disorder. Mol. Genet. Metab. 2004, 83, 6–15. [Google Scholar] [CrossRef] [PubMed]
- La Morgia, C.; di Vito, L.; Carelli, V.; Carbonelli, M. Patterns of retinal ganglion cell damage in neurodegenerative disorders: Parvocellular vs magnocellular degeneration in optical coherence tomography studies. Front. Neurol. 2017, 8, 1–10. [Google Scholar] [CrossRef]
- Costello, F.E. Optical coherence tomography technologies: Which machine do you want to own? J. Neuro-Ophthalmol. 2014, 34, S3–S9. [Google Scholar] [CrossRef]
- Winter, A.W.; Salimi, A.; Ospina, L.H.; Roos, J.C.P. Ophthalmic manifestations of Gaucher disease: The most common lysosomal storage disorder. Br. J. Ophthalmol. 2019, 103, 315–326. [Google Scholar] [CrossRef] [PubMed]
- McNeill, A.; Roberti, G.; Lascaratos, G.; Hughes, D.; Mehta, A.; Garway-Heath, D.F.; Schapira, A.H.V. Retinal thinning in Gaucher disease patients and carriers: Results of a pilot study. Mol. Genet. Metab. 2013, 109, 221–223. [Google Scholar] [CrossRef] [PubMed]
- Matos, A.G.; Gurgel, V.P.; Gonçalves, M.C. Ophthalmologic findings in Gaucher’s disease type III: Case report. Rev. Bras. Oftalmol. 2017, 76, 316–318. [Google Scholar] [CrossRef]
- Casson, R.J.; Chidlow, G.; Wood, J.P.M. Estimate of the adenosine triphosphate requirement of human retinal ganglion cells. Clin. Exp. Ophthalmol. 2019, 47, 683–684. [Google Scholar] [CrossRef]
- Carelli, V.; La Morgia, C.; Ross-Cisneros, F.N.; Sadun, A.A. Optic neuropathies: The tip of the neurodegeneration iceberg. Hum. Mol. Genet. 2017, 26, R139–R150. [Google Scholar] [CrossRef]
- Corredor, R.G.; Goldberg, J.L. Retinal Ganglion Cell Life and Death—Mechanisms and Implications for Ophthalmology. Eur. Ophthalmic Rev. 2009, 3, 109. [Google Scholar] [CrossRef]
- Bruscolini, A.; Pia Pirraglia, M.; Restivo, L.; Spinucci, G.; Abbouda, A. A branch retinal artery occlusion in a patient with Gaucher disease. Graefe’s Arch. Clin. Exp. Ophthalmol. 2012, 250, 441–444. [Google Scholar] [CrossRef]
- Tumbarello, D.A.; Turner, C.E. Hic-5 Contributes to Transformation Through a RhoA/ROCK-dependent Pathway. J. Cell. Physiol. 2006, 211, 736–747. [Google Scholar] [CrossRef]
- Cleeter, M.W.J.; Chau, K.Y.; Gluck, C.; Mehta, A.; Hughes, D.A.; Duchen, M.; Wood, N.W.; Hardy, J.; Mark Cooper, J.; Schapira, A.H. Glucocerebrosidase inhibition causes mitochondrial dysfunction and free radical damage. Neurochem. Int. 2013, 62, 1–7. [Google Scholar] [CrossRef]
- Mead, B.; Tomarev, S. Evaluating retinal ganglion cell loss and dysfunction. Exp. Eye Res. 2016, 151, 96–106. [Google Scholar] [CrossRef]
- Smith, C.A.; Vianna, J.R.; Chauhan, B.C. Assessing retinal ganglion cell damage. Eye 2017, 31, 209–217. [Google Scholar] [CrossRef] [PubMed]
- You, Y.; Gupta, V.K.; Li, J.C.; Klistorner, A.; Graham, S.L. Optic neuropathies: Characteristic features and mechanisms of retinal ganglion cell loss. Rev. Neurosci. 2013, 24, 301–321. [Google Scholar] [CrossRef] [PubMed]
- Langeveld, M.; Elstein, D.; Szer, J.; Hollak, C.E.M.; Zimran, A. Classifying the additional morbidities of Gaucher disease. Blood Cells Mol. Dis. 2018, 68, 209–210. [Google Scholar] [CrossRef] [PubMed]
- O’Regan, G.; Desouza, R.M.; Balestrino, R.; Schapira, A.H. Glucocerebrosidase Mutations in Parkinson Disease. J. Parkinson’s Dis. 2017, 7, 411–422. [Google Scholar] [CrossRef]
- Rolfs, A.; Giese, A.K.; Grittner, U.; Mascher, D.; Elstein, D.; Zimran, A.; Böttcher, T.; Lukas, J.; Hübner, R.; Gölnitz, U.; et al. Glucosylsphingosine is a highly sensitive and specific biomarker for primary diagnostic and follow-up monitoring in gaucher disease in a non-jewish, caucasian cohort of gaucher disease patients. PLoS ONE 2013, 8, 1–9. [Google Scholar] [CrossRef]
- Zimran, A.; Gross, E.; West, C.; Sorge, J.; Kubitz, M.; Beutler, E. Prediction of Severity of Gaucher’S Disease By Identification of Mutations At Dna Level. Lancet 1989, 334, 349–352. [Google Scholar] [CrossRef]
- Sibille, A.; Eng, C.M.; Kim, S.J.; Pastores, G.; Grabowski, G.A. Phenotype/genotype correlations in Gaucher disease type 1: Clinical and therapeutic implications. Am. J. Hum. Genet. 1993, 52, 1094–1101. [Google Scholar]
- Treatment, E.; Retinopathy, D. Grading Diabetic Retinopathy from Stereoscopic Color Fundus Photographs—An Extension of the Modified Airlie House Classification: ETDRS Report Number 10. Ophthalmology 1991, 98, 786–806. [Google Scholar] [CrossRef]

| Control Group | Gaucher Patients | p Value | |
|---|---|---|---|
| Males (%) | 13 (43.3%) | 16 (53.3%) | 0.492 |
| Age (years) | 51.17 ± 8.93 | 51.10 ± 9.79 | 0.729 |
| Refraction (D) | −0.78 ± 2.14 | −1.28 ± 2.30 | 0.542 |
| Control Eyes (n = 60) | Gaucher eyes (n = 60) | p Value | |
|---|---|---|---|
| Macular OCT quality | 62.97 ± 5.17 | 61.28 ± 6.35 | 0.142 |
| Macular volume (mm3) | 7.69 ± 0.38 | 7.66 ± 0.27 | 0.648 |
| Macular retinal thickness (µm) | 271.98 ± 13.34 | 270.82 ± 9.62 | 0.631 |
| Optic nerve OCT quality | 62.62 ± 4.15 | 61.5 ± 5.02 | 0.196 |
| Abnormal optic nerve scans (%) | 5 (8.3%) | 22 (36.7%) | <0.001 |
| Peripapillary RNFL (µm) | |||
| Average | 106.40 ± 8.78 | 97.63 ± 8.42 | <0.001 |
| Temporal | 73.63 ± 11.81 | 69.13 ± 13.40 | 0.220 |
| Superior | 130.57 ± 11.55 | 118.78 ± 16.15 | <0.001 |
| Nasal | 83.30 ± 15.73 | 77.38 ± 22.04 | 0.015 |
| Inferior | 138.07 ± 18.09 | 125.20 ± 16.36 | <0.001 |
| Macular GCC layer (µm) | |||
| Total average | 73.92 ± 4.90 | 72.60 ± 4.84 | 0.557 |
| Outer Average | 64.89 ± 4.63 | 62.83 ± 4.69 | 0.226 |
| central | 47.70 ± 10.88 | 50.03 ± 10.34 | 0.110 |
| inner temporal | 86.70 ± 6.48 | 85.28 ± 7.64 | 0.417 |
| Inner superior | 91.07 ± 6.52 | 89.02 ± 8.38 | 0.250 |
| Inner nasal | 92.02 ± 7.24 | 89.77 ± 7.71 | 0.281 |
| Inner inferior | 88.28 ± 8.55 | 88.03 ± 7.51 | 0.646 |
| Outer temporal | 68.17 ± 5.49 | 66.65 ± 5.28 | 0.091 |
| Outer superior | 60.12 ± 4.63 | 59.58 ± 5.08 | 0.315 |
| Outer nasal | 68.02 ± 5.24 | 65.17 ± 6.17 | 0.003 |
| outer inferior | 63.92 ± 6.55 | 59.95 ± 6.50 | 0.002 |
© 2020 by the authors. Licensee MDPI, Basel, Switzerland. This article is an open access article distributed under the terms and conditions of the Creative Commons Attribution (CC BY) license (http://creativecommons.org/licenses/by/4.0/).
Share and Cite
Weill, Y.; Zimran, A.; Zadok, D.; Wasser, L.M.; Revel-Vilk, S.; Hanhart, J.; Dinur, T.; Arkadir, D.; Becker-Cohen, M. Macular Ganglion Cell Complex and Peripapillary Retinal Nerve Fiber Layer Thinning in Patients with Type-1 Gaucher Disease. Int. J. Mol. Sci. 2020, 21, 7027. https://doi.org/10.3390/ijms21197027
Weill Y, Zimran A, Zadok D, Wasser LM, Revel-Vilk S, Hanhart J, Dinur T, Arkadir D, Becker-Cohen M. Macular Ganglion Cell Complex and Peripapillary Retinal Nerve Fiber Layer Thinning in Patients with Type-1 Gaucher Disease. International Journal of Molecular Sciences. 2020; 21(19):7027. https://doi.org/10.3390/ijms21197027
Chicago/Turabian StyleWeill, Yishay, Ari Zimran, David Zadok, Lauren M. Wasser, Shoshana Revel-Vilk, Joel Hanhart, Tama Dinur, David Arkadir, and Michal Becker-Cohen. 2020. "Macular Ganglion Cell Complex and Peripapillary Retinal Nerve Fiber Layer Thinning in Patients with Type-1 Gaucher Disease" International Journal of Molecular Sciences 21, no. 19: 7027. https://doi.org/10.3390/ijms21197027
APA StyleWeill, Y., Zimran, A., Zadok, D., Wasser, L. M., Revel-Vilk, S., Hanhart, J., Dinur, T., Arkadir, D., & Becker-Cohen, M. (2020). Macular Ganglion Cell Complex and Peripapillary Retinal Nerve Fiber Layer Thinning in Patients with Type-1 Gaucher Disease. International Journal of Molecular Sciences, 21(19), 7027. https://doi.org/10.3390/ijms21197027

